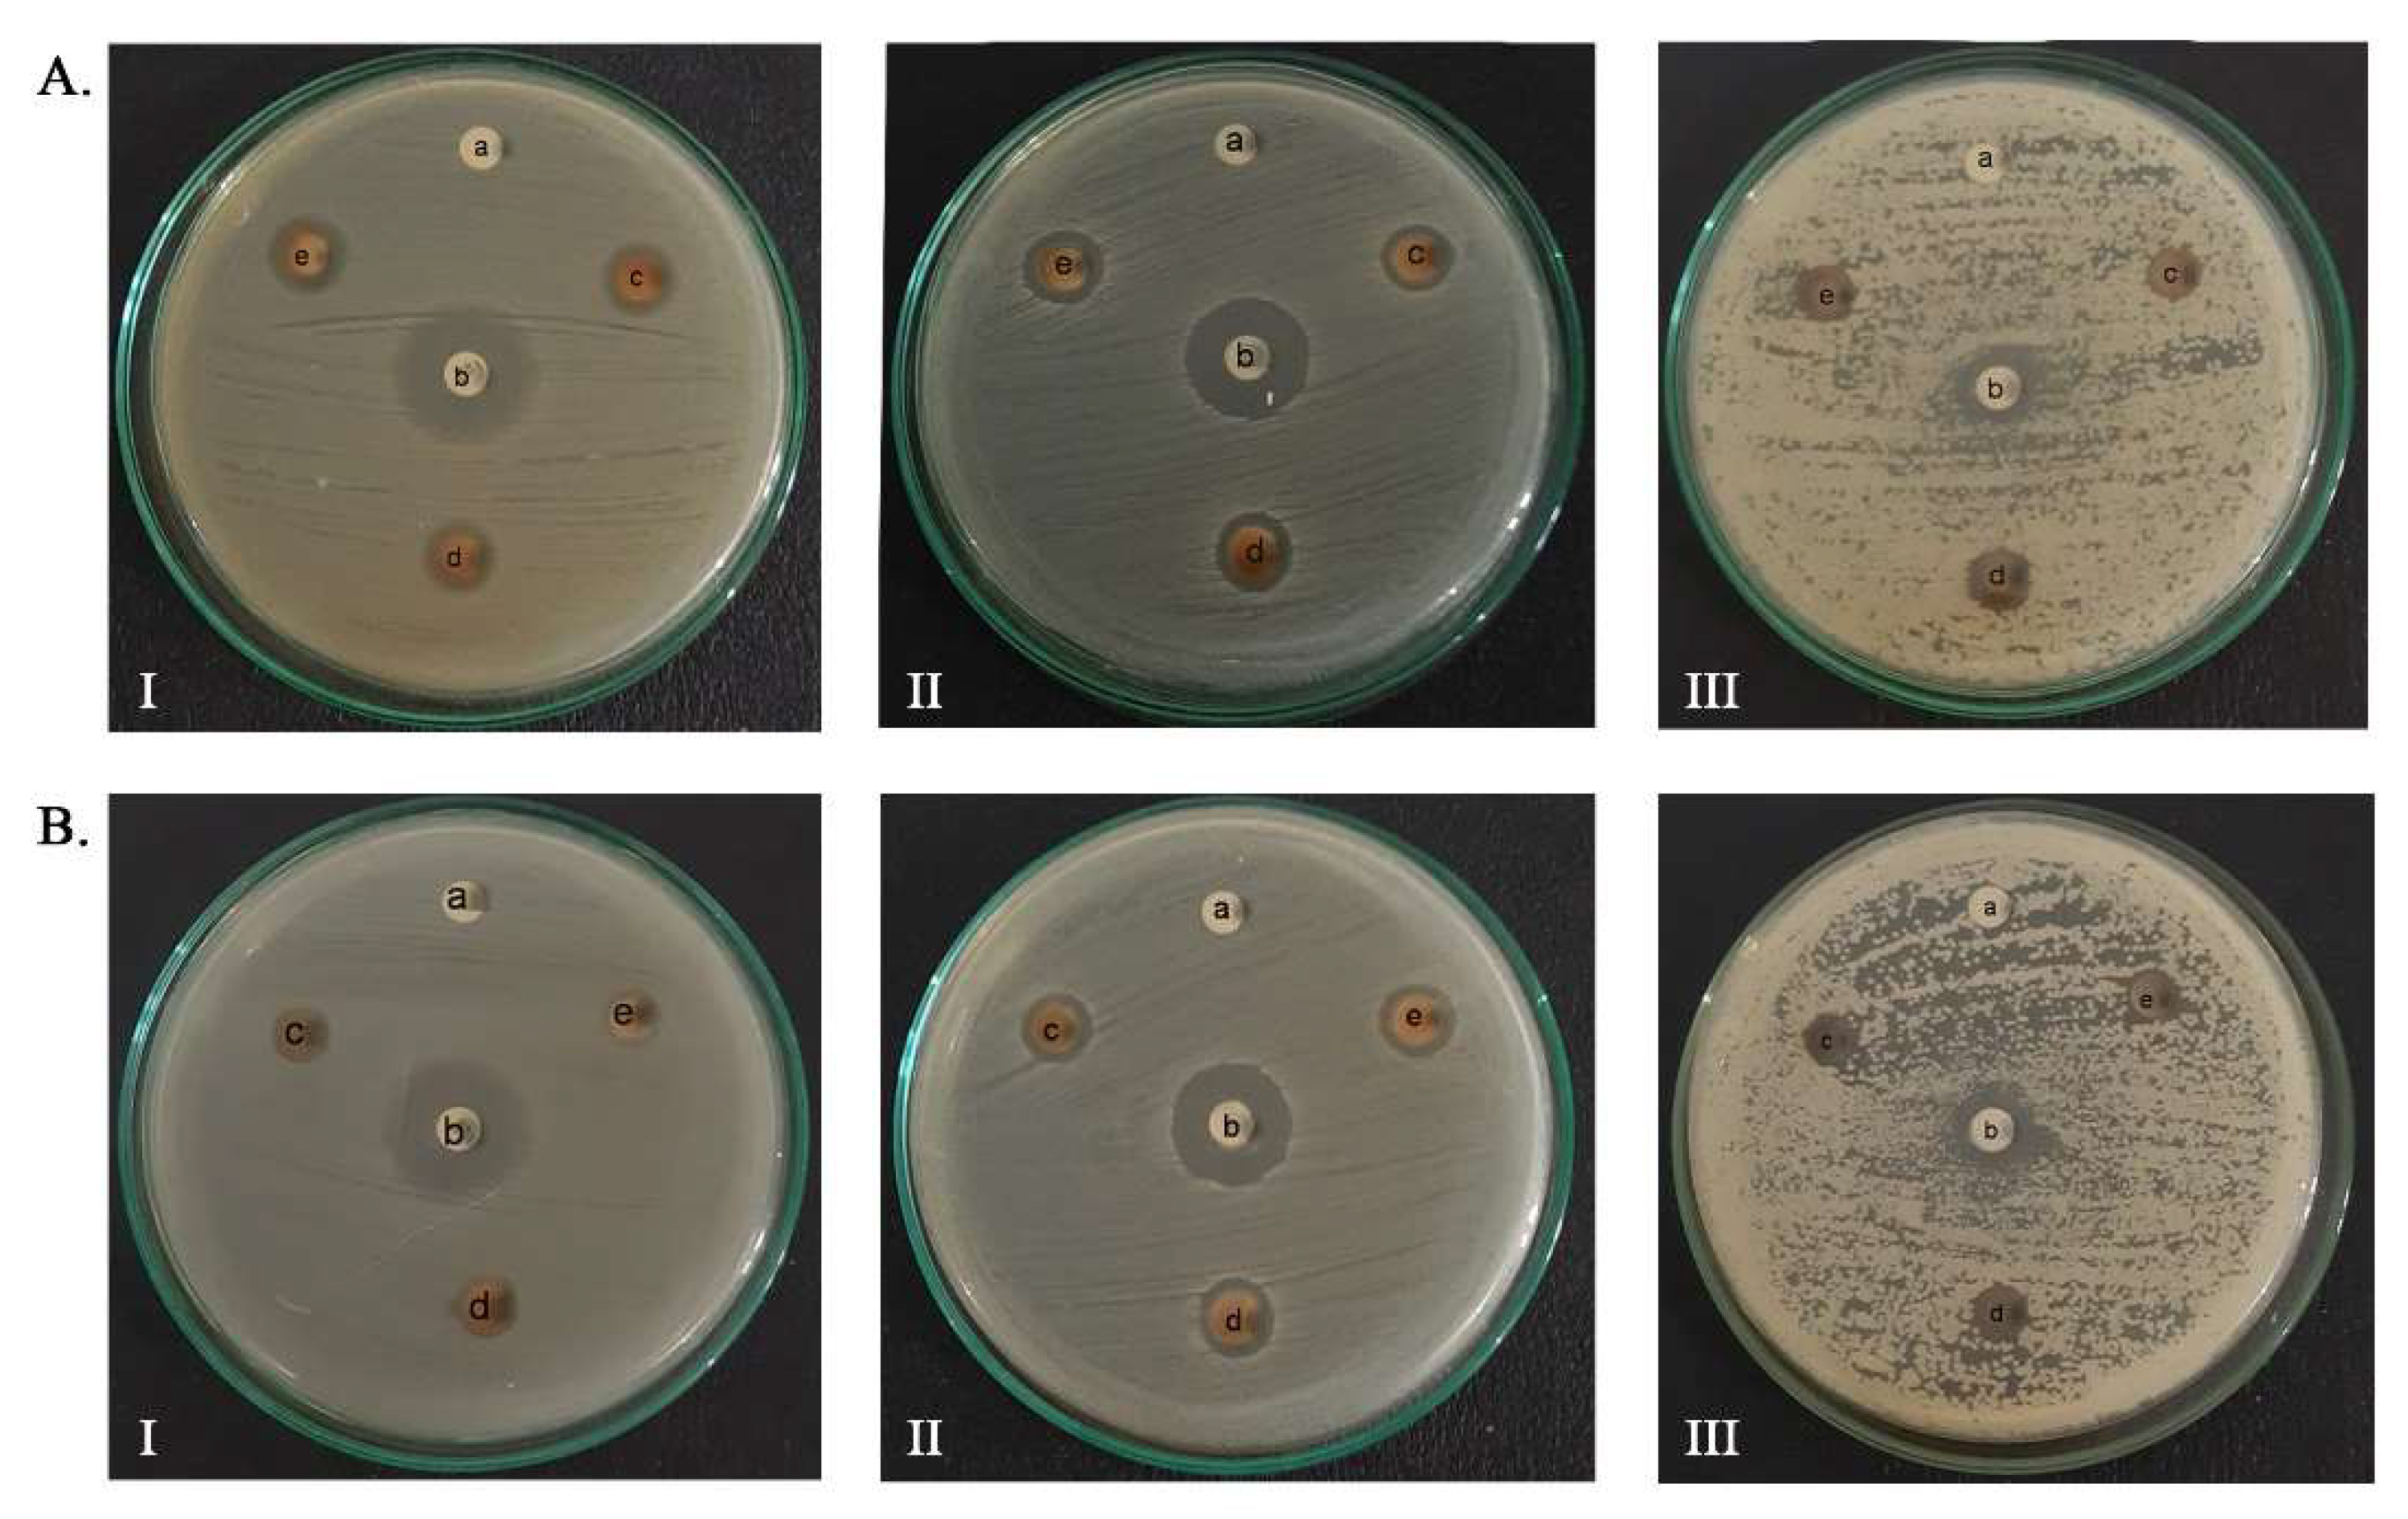
Molecules 27 05310 g006 550

Green Synthesis and Antimicrobial Activities of Silver Nanoparticles Using Calotropis gigantea from Ie Seu-Um Geothermal Area, Aceh Province, Indonesia
Abstract
:1. Introduction
2. Results and Discussion
2.1. Green Synthesis AgNPs-LCg and AgNPs-FCg
2.2. Characterization of Silver Nanoparticles (AgNPs-LCg and AgNPs-FCg)
2.2.1. UV–Vis Spectrophotometry Analysis
2.2.2. Fourier Transform Infrared (FTIR) Analysis
2.2.3. SEM-EDS Analysis
2.2.4. Zeta Potential Analysis
2.3. Antimicrobial Activity of Silver Nanoparticles (AgNPs-LCg and AgNPs-FCg)
3. Materials and Methods
3.1. Materials and Bioindicators
3.2. Plant Extraction
3.3. Phytochemical Test
3.4. Green Synthesis of AgNPs
3.5. Characterization of Silver Nanoparticles (AgNPs-LCg and AgNPs-FCg)
3.6. Antimicrobial Activity Assay
4. Conclusions
Author Contributions
Funding
Institutional Review Board Statement
Informed Consent Statement
Data Availability Statement
Acknowledgments
Conflicts of Interest
Sample Availability
References
- Tallei, T.E.; Yelnetty, A.; Marfuah, S. Evaluation of the Potential for Immunomodulatory and Anti-Inflammatory Properties of Phytoconstituents Derived from Pineapple [Ananas comosus (L.) Merr.] Peel Extract Using an In Silico Approach. Philipp. J. Sci. 2022, 151, 397–410. [Google Scholar]
- Khairan, K.; Astuti, Y.; First, I.S. Gel Formulation of Ethyl Acetate Garlic Extraction and Its Activity Against Staphylococcus Epidermis. J. Chem. Nat. Resour. 2019, 1, 69–78. [Google Scholar] [CrossRef]
- Khairan, K.; Septiya, S. Murniana Antibacterial Activity of Magnolia Alba Flower Extracts on Staphylococcus Epidermidis and Staphylococcus Aureus. In IOP Conference Series: Earth and Environmental Science, Proceedings of the 10th Annual International Conference (AIC) on Environmental and Life Sciences (ELS), Banda Aceh, Indonesia, 15–16 October 2020; IOP Publishing: Bristol, UK, 2021; Volume 711, p. 711. [Google Scholar] [CrossRef]
- Seriana, I.; Akmal, M.; Darusman; Wahyuni, S.; Khairan, K. Sugito Phytochemicals Characterizations of Neem (Azadirachta indica A. Juss) Leaves Ethanolic Extract: An Important Medicinal Plant as Male Contraceptive Candidate. Rasayan J. Chem. 2021, 14, 343–350. [Google Scholar] [CrossRef]
- Khairan, K.; Aulina, A.; Yusra, N.; Eriana, C.N.; Bahi, M.; Syaukani, S.; Sriwati, R.; Jacob, C. Termiticidal and Nematicidal Activities of Five Extracts from Garlic (Allium sativum). In Journal of Physics: Conference Series, Volume 1882, The 1st South East Asia Science, Technology, Engineering and Mathematics International Conference (SEA-STEM IC) 2020, Banda Aceh, Indonesia, 20–22 October 2020; IOP Publishing: Bristol, UK, 2021; Volume 1882. [Google Scholar] [CrossRef]
- Mousavi, S.S.; Karami, A.; Haghighi, T.M.; Tumilaar, S.G.; Fatimawali; Idroes, R.; Mahmud, S.; Celik, I.; Ağagündüz, D.; Tallei, T.E.; et al. In Silico Evaluation of Iranian Medicinal Plant Phytoconstituents as Inhibitors against Main Protease and the Receptor-Binding Domain of Sars-Cov-2. Molecules 2021, 26, 5724. [Google Scholar] [CrossRef]
- Khairan, K.; Idroes, R.; Tumilaar, S.G.; Tallei, T.E.; Idroes, G.M.; Rahmadhany, F.; Futri, M.U.; Dinura, N.M.; Mauliza, S.; Diana, M.; et al. Molecular Docking Study of Fatty Acids from Pliek U Oil in the Inhibition of SARS-CoV-2 Protein and Enzymes. In IOP Conference Series: Materials Science and Engineering, The 10th Annual International Conference on Science and Engineering (10th AIC 2020), Banda Aceh, Indonesia, 15–16 October 2020; IOP Publishing: Bristol, UK, 2021; Volume 1087. [Google Scholar] [CrossRef]
- Tallei, T.E.; Tumilaar, S.G.; Niode, N.J.; Fatimawali, F.; Kepel, B.J.; Idroes, R.; Effendi, Y. Potential of Plant Bioactive Compounds as SARS-CoV-2 Main Protease (Mpro) and Spike (S) Glycoprotein Inhibitors: A Molecular Docking Study. Scientifica 2020, 2020, 6307457. [Google Scholar] [CrossRef]
- Dutta, M.; Nezam, M.; Chowdhury, S.; Rakib, A.; Paul, A.; Sami, S.A.; Uddin, M.Z.; Rana, M.S.; Hossain, S.; Effendi, Y.; et al. Appraisals of the Bangladeshi Medicinal Plant Calotropis Gigantea Used by Folk Medicine Practitioners in the Management of COVID-19: A Biochemical and Computational Approach. Front. Mol. Biosci. 2021, 8, 625391. [Google Scholar] [CrossRef]
- Abubakar, A.; Yusuf, H.; Syukri, M.; Nasution, R.; Karma, T.; Munawar, A.A.; Idroes, R. Chemometric Classification of Geothermal and Non-Geothermal Ethanol Leaf Extract of Seurapoh (Chromolaena odorata Linn) Using Infrared Spectroscopy. Earth Environ. Sci. 2021, 667, 012070. [Google Scholar] [CrossRef]
- Nuraskin, C.; Marlina; Idroes, R.; Soraya, C. Djufri Identification of Secondary Metabolite of Laban Leaf Extract (Vitex pinnata L) from Geothermal Areas and Non-Geothermal of Agam Mountains in Aceh Besar, Aceh Province, Indonesia. Rasayan, J. Chem. 2020, 13, 18–23. [Google Scholar] [CrossRef]
- Idroes, R.; Yusuf, M.; Saiful, S.; Alatas, M.; Subhan, S.; Lala, A.; Muslem, M.; Suhendra, R.; Idroes, G.M.; Marwan, M.; et al. Geochemistry Exploration and Geothermometry Application in the North Zone of Seulawah Agam, Aceh Besar District, Indonesia. Energies 2019, 12, 4442. [Google Scholar] [CrossRef] [Green Version]
- Idroes, R.; Marwan, M.; Yusuf, M.; Muslem, M.; Helwani, Z. Geochemical Investigation on Jaboi Manifestation, Jaboi Volcano, Sabang, Indonesia. Int. J. Geomate 2021, 20, 170–185. [Google Scholar] [CrossRef]
- Marwan, M.; Yanis, M.; Nugraha, G.S.; Zainal, M.; Arahman, N.; Idroes, R.; Dharma, D.B.; Saputra, D.; Gunawan, P. Mapping of Fault and Hydrothermal System beneath the Seulawah Volcano Inferred from a Magnetotellurics Structure. Energies 2021, 14, 6091. [Google Scholar] [CrossRef]
- Idroes, R.; Yusuf, M.; Alatas, M.; Subhan; Lala, A.; Muslem; Suhendra, R.; Idroes, G.M.; Suhendrayatna; Marwan; et al. Geochemistry of Warm Springs in the Ie Brôuk Hydrothermal Areas at Aceh Besar District. In IOP Conference Series: Materials Science and Engineering, The 8th Annual International Conference (AIC) 2018 on Science and Engineering, Banda Aceh, Indonesia, 12–14 September 2018; IOP Publishing: Bristol, UK, 2019; Volume 523. [Google Scholar] [CrossRef]
- Idroes, R.; Yusuf, M.; Alatas, M.; Subhan, S.; Lala, A.; Saiful, S.; Suhendra, R.; Idroes, G.M.; Marwan, M. Geochemistry of Hot Springs in the Ie Seu’um Hydrothermal Areas at Aceh Besar District, Indonesia. In IOP Conference Series: Materials Science and Engineering, The 3rd International Conference on Chemical Engineering Sciences and Applications 2017 (3rd ICChESA 2017), Banda Aceh, Indonesia, 20–21 September 2017; IOP Publishing: Bristol, UK, 2018; Volume 334. [Google Scholar] [CrossRef]
- Idroes, R.; Yusuf, M.; Alatas, M.; Subhan; Lala, A.; Muhammad; Suhendra, R.; Idroes, G.M.; Marwan. Geochemistry of Sulphate Spring in The Ie Jue Geothermal Areas at Aceh Besar District, Indonesia. In IOP Conference Series: Materials Science and Engineering, The 8th Annual International Conference (AIC) 2018 on Science and Engineering, Banda Aceh, Indonesia, 12–14 September 2018; IOP Publishing: Bristol, UK, 2019; Volume 523. [Google Scholar]
- Ningsih, D.S.; Idroes, R. In Vitro Cytotoxicity of Ethanolic Extract of The Leaf of Calotropis Gigantea from Ie Jue Geothermal Area, Aceh-Indonesia, And Its Mouthwash Formulation Against Dental Pulp Cells. J. Apllied Pharm. Sci. 2022, 12, 133–143. [Google Scholar] [CrossRef]
- Idroes, G.M.; Tallei, T.E.; Idroes, R.; Muslem; Riza, M.; Suhendrayatna. The Study of Calotropis Gigantea Leaf Metabolites from Ie Brouk Geothermal Area Lamteuba-Aceh Besar Using Molecular Docking. In IOP Conference Series: Earth and Environmental Science, The 2nd International Conference on Agriculture and Bio-industry, Banda Aceh, Indonesia, 27–28 October 2020; IOP Publishing: Bristol, UK, 2021; Volume 667. [Google Scholar] [CrossRef]
- Idroes, R.; Khairan, K.; Fakri, F.; Zulfendi, Z. Skrining Aktifitas Tumbuhan Yang Berpotensi Sebagai Bahan Antimikroba Di Kawasan Ie Seu Um Aceh Besar; Syiah Kuala Universiti Press: Banda Aceh, Indonesia, 2016; ISBN 978-602-1270-52-3. [Google Scholar]
- Bruna, T.; Maldonado-Bravo, F.; Jara, P.; Caro, N. Silver Nanoparticles and Their Antibacterial Applications. Int. J. Mol. Sci. 2021, 22, 7202. [Google Scholar] [CrossRef] [PubMed]
- Agnihotri, S.; Mukherji, S.; Mukherji, S. Immobilized Silver Nanoparticles Enhance Contact Killing and Show Highest Efficacy: Elucidation of The Mechanism of Bactericidal Action of Silver. Nanoscale 2013, 5, 7328–7340. [Google Scholar] [CrossRef] [Green Version]
- Quinteros, M.A.; Cano Aristizábal, V.; Dalmasso, P.R.; Paraje, M.G.; Páez, P.L. Oxidative Stress Generation of Silver Nanoparticles in Three Bacterial Genera and Its Relationship with The Antimicrobial Activity. Toxicol. Vitr. 2016, 36, 216–223. [Google Scholar] [CrossRef]
- Gomaa, E.Z. Silver Nanoparticles as an Antimicrobial Agent: A Case Study on Staphylococcus Aureus and Escherichia Coli as Models for Gram-Positive and Gram-Negative Bacteria. J. Gen. Appl. Microbiol. 2017, 63, 36–43. [Google Scholar] [CrossRef] [PubMed] [Green Version]
- SIlva, M.C.; Werlang, H.M.; Vanddresen, D.; Fortes, P.C.; Pascotto, C.R.; Lucio, L.C.; Ferreto, L.E. Genetic, Antimicrobial Resistance Profile and Mortality Rates of Acinetobacter Baumannii Infection in Brazil: A Systematic Review. Narra J. 2022, 2, e68. [Google Scholar] [CrossRef]
- Harahap, D.; Niaci, S.; Mardina, V.; Zaura, B.; Qanita, I.; Purnama, A.; Pispita, K.; Rizki, D.R.; Iqhrammullah, M. Antibacterial Activities of Seven Ethnomedicinal Plants from Family Annonaceae. J. Adv. Pharm. Technol. Res. 2022, 13, 148–153. [Google Scholar] [CrossRef]
- Salayov, A.; Bedlovičová, Z. Green Synthesis of Silver Nanoparticles with Antibacterial Activity Using Various Medicinal Plant Extracts: Morphology and Antibacterial Efficacy. Nanomaterials 2021, 11, 1005. [Google Scholar] [CrossRef]
- Jain, A.S.; Pawar, P.S.; Sarkar, A.; Junnuthula, V.; Dyawanapelly, S. Bionanofactories for Green Synthesis of Silver Nanoparticles: Toward Antimicrobial Applications. Int. J. Mol. Sci. 2021, 22, 11993. [Google Scholar] [CrossRef]
- Sharma, V.; Kaushik, S.; Pandit, P.; Dhull, D.; Yadav, J.P.; Kaushik, S. Green Synthesis of Silver Nanoparticles From Medicinal Plants And Evaluation of Their Antiviral Potential Against Chikungunya Virus. Appl. Microbiol. Biotechnol. 2019, 103, 881–891. [Google Scholar] [CrossRef] [PubMed]
- Anbu, P.; Gopinath, S.C.B.; Shik, H.; Lee, C. Temperature-Dependent Green Biosynthesis and Characterization of Silver Nanoparticles Using Balloon Fl Ower Plants and Their Antibacterial Potential. J. Mol. Struct. 2019, 1177, 302–309. [Google Scholar] [CrossRef]
- Tanase, C.; Berta, L.; Coman, A.; Ros, I.; Man, A.; Toma, F.; Mocan, A.; Nicolescu, A.; Jakab-farkas, L. Antibacterial and Antioxidant Potential of Silver Nanoparticles Biosynthesized Using the Spruce Bark Extract. Nanomaterials 2019, 9, 1541. [Google Scholar] [CrossRef] [PubMed] [Green Version]
- Gemishev, O.; Panayotova, M.; Gicheva, G.; Mintcheva, N. Green Synthesis of Stable Spherical Monodisperse Silver Nanoparticle Using a Cell-Free Extract of Trichoderma Reesei. Materials 2022, 15, 481. [Google Scholar] [CrossRef]
- Al-otibi, F.; Perveen, K.; Al-saif, N.A.; Alharbi, R.I.; Bokhari, N.A.; Albasher, G.; Al-otaibi, R.M.; Al-mosa, M.A. Biosynthesis of Silver Nanoparticles Using Malva Parviflora and Their Antifungal Activity. Saudi J. Biol. Sci. 2021, 28, 2229–2235. [Google Scholar] [CrossRef]
- Mathew, S.; Victo, C.P.; Sidhi, J.; Thanzeela, B. Biosynthesis of Silver Nanoparticle Using Flowers of Calotropis gigantea (L.) W.T. Aiton and Activity Against Pathogenic Bacteria. Arab. J. Chem. 2020, 13, 9139–9144. [Google Scholar] [CrossRef]
- Haggag, E.G.; Elshamy, A.M.; Rabeh, M.A.; Gabr, N.M.; Salem, M.; Youssif, K.A.; Samir, A.; Bin Muhsinah, A.; Alsayari, A.; Abdelmohsen, U.R. Antiviral Potential of Green Synthesized Silver Nanoparticles of Lampranthus Coccineus And Malephora Lutea. Int. J. Nanomed. 2019, 14, 6217–6229. [Google Scholar] [CrossRef] [Green Version]
- Rakib-Uz-Zaman, S.M.; Apu, E.H.; Muntasir, M.N.; Mowna, S.A.; Khanom, M.G.; Jahan, S.S.; Akter, N.; Khan, M.A.R.; Shuborna, N.S.; Shams, S.M.; et al. Biosynthesis of Silver Nanoparticles from Cymbopogon Citratus Leaf Extract and Evaluation of Their Antimicrobial Properties. Challeges 2022, 13, 18. [Google Scholar] [CrossRef]
- Alahmad, A.; Al-zereini, W.A.; Hijazin, T.J.; Al-madanat, O.Y.; Alghoraibi, I.; Al-qaralleh, O.; Al-qaraleh, S.; Feldhoff, A.; Walter, J.; Scheper, T. Green Synthesis of Silver Nanoparticles Using Hypericum perforatum L. Aqueous Extract with the Evaluation of Its Antibacterial Activity against Clinical and Food Pathogens. Pharmaceutics 2022, 14, 1104. [Google Scholar] [CrossRef]
- Govindan, L.; Anbazhagan, S.; Altemimi, A.B.; Lakshminarayanan, K.; Kuppan, S.; Pratap-Singh, A.; Kandasamy, M. Efficacy of Antimicrobial and Larvicidal Activities of Green Synthesized Silver Nanoparticle Using Leaf Extract of Plumbago Auriculata Lam. Plants 2020, 9, 1577. [Google Scholar] [CrossRef]
- Pryshchepa, O.; Pomastowski, P.; Buszewski, B. Silver Nanoparticles: Synthesis, Investigation Techniques, and Properties. Adv. Colloid Interface Sci. 2020, 284, 87–100. [Google Scholar] [CrossRef] [PubMed]
- Ali, E.M.; Abdallah, B.M. Effective Inhibition of Candidiasis Using an Eco- Friendly Leaf Extract of Calotropis-Gigantean-Mediated Silver Nanoparticles. Nanomaterials 2020, 10, 422. [Google Scholar] [CrossRef] [PubMed] [Green Version]
- Ali, D.M.; Sasikala, M.; Gunasekaran, M.; Thajuddin, N. Biosynthesis and Characterization of Silver Nanoparticles Using Marine Cyanobacterium, Oscillatoria Willei NTDM01. J. Nanomater. Biostruct. 2011, 6, 385–390. [Google Scholar]
- Mirda, E.; Idroes, R.; Khairan, K.; Tallei, T.E.; Ramli, M.; Earlia, N.; Maulana, A.; Idroes, G.M.; Muslem, M.; Jalil, Z. Synthesis of Chitosan-Silver Nanoparticle Composite Spheres and Their Antimicrobial Activities. Polymers 2021, 13, 3990. [Google Scholar] [CrossRef]
- Almatroudi, A.; Khadri, H.; Azam, M.; Rahmani, A.H.; Khaleefah, F.; Khaleefah, A.; Khateef, R.; Ansari, M.A.; Allemailem, K.S. Antibacterial, Antibiofilm and Anticancer Activity of Biologically Synthesized Silver Nanoparticles Using Seed Extract of Nigella Sativa. Processes 2020, 8, 388. [Google Scholar] [CrossRef] [Green Version]
- Kambale, E.K.; Nkanga, C.I.; Mutonkole, B.P.I.; Bapolisi, A.M.; Tassa, D.O.; Liesse, J.M.I.; Krause, R.W.M.; Memvanga, P.B. Green Synthesis of Antimicrobial Silver Nanoparticles Using Aqueous Leaf Extracts from Three Congolese Plant Species (Brillantaisia patula, Crossopteryx febrifuga and Senna siamea). Heliyon 2020, 6, e04493. [Google Scholar] [CrossRef]
- Alsalhi, M.S.; Elangovan, K.; Jacob, A.; Ranjitsingh, A.; Murali, P.; Devanesan, S. Synthesis of Silver Nanoparticles Using Plant Derived 4-N-Methyl Benzoic Acid And Evaluation of Antimicrobial, Antioxidant And Antitumor Activity. Saudi J. Biol. Sci. 2019, 26, 970–978. [Google Scholar] [CrossRef]
- Kokila, T.; Ramesh, P.S.; Geetha, D. Biosynthesis of AgNPs Using Carica Papaya Peel Extract and Evaluation of Its Antioxidant and Antimicrobial Activities. Ecotoxicol. Environ. Saf. 2016, 134, 467–473. [Google Scholar] [CrossRef]
- Venkatachalam, S. Chapter 6. Ultraviolet and Visible Spectroscopy Studies of Nanofillers and Their Polymer Nanocomposites; Elsevier Inc.: Amsterdam, The Netherlands, 2016; ISBN 9780323401838. [Google Scholar]
- Jaswal, T.; Gupta, J. A Review on the Toxicity of Silver Nanoparticles on Human Health. Mater. Today Proc. 2021, 1–5. [Google Scholar] [CrossRef]
- Al-otibi, F.; Al-ahaidib, R.A.; Alharbi, R.I.; Al-otaibi, R.M.; Albasher, G. Antimicrobial Potential of Biosynthesized Silver Nanoparticles by Aaronsohnia Factorovskyi Exract. Molecules 2021, 26, 130. [Google Scholar] [CrossRef]
- Pietta, P.G. Flavonoids as Antioxidants. J. Nat. Prod. 2000, 63, 1035–1042. [Google Scholar] [CrossRef] [PubMed]
- Van Acker, S.A.B.E.; Van Den Berg, D.J.; Tromp, M.N.J.L.; Griffioen, D.H.; Van Bennekom, W.P.; Van Der Vijgh, W.J.F.; Bast, A. Structural Aspects of Antioxidant Activity of Flavonoids. Free Radic. Biol. Med. 1996, 20, 331–342. [Google Scholar] [CrossRef]
- Nayem, S.M.A.; Sultana, N.; Haque, A.; Miah, B.; Hasan, M.; Islam, T.; Mahedi, H.; Awal, A.; Uddin, J.; Aziz, A.; et al. Green Synthesis of Gold and Silver Nanoparticles by Using Amorphophallus paeoniifolius Tuber Extract and Evaluation of Their Antibacterial Activity. Molecules 2020, 25, 4773. [Google Scholar] [CrossRef] [PubMed]
- Chouhan, S.; Guleria, S. Green Synthesis of AgNPs Using Cannabis Sativa Leaf Extract: Characterization, Antibacterial, Anti-Yeast and Alpha-Amylase Inhibitory Activity. Mater. Sci. Energy Technol. 2020, 3, 536–544. [Google Scholar] [CrossRef]
- Musman, M. Kimia Bahan Alam Laut; Syiah Kuala University Press: Banda Aceh, Indonesia, 2013; ISBN 9789798278938. [Google Scholar]
- Sorubavalli, U.; Vadivazhagi, M.K.; Vadivelu, J. Antioxidant and Antimicrobial Activity of Calotrophis Mediated Silver Nanoparticles. J. Compos. Theory 2019, XII, 303–312. [Google Scholar]

| Secondary Metabolites | AgNPs-FCg | AgNPs-LCg |
|---|---|---|
| Saponins | +(ve) | +(ve) |
| Phenolic | +(ve) | +(ve) |
| Tannins | +(ve) | +(ve) |
| Flavonoids | +(ve) | −(ve) |
| Terpenoids | +(ve) | −(ve) |
| Steroids | −(ve) | +(ve) |
| Alkaloids | +(ve) | +(ve) |
| [AgNO3] | AgNPs-FCg (Mean ± SD) | AgNPs-LCg (Mean ± SD) | ||
|---|---|---|---|---|
| Stability (mV) | Size (nm) | Stability (mV) | Size (nm) | |
| 2 mM | −33.05 ± 0.00 | 256.7 ± 2.82 | −40.5 ± 0.56 | 227.65 ± 0.07 |
| 5 mM | −30.3 ± 0.00 | 200.8 ± 0.14 | −41.8 ± 0.14 | 87.85 ± 0.91 |
| 9 mM | −25.1 ± 0.00 | 163.5 ± 1.06 | −31.35 ± 0.7 | 188.35 ± 3.32 |
| Sample | Concentration of [AgNO3] (mM) | Inhibition Zone, Mean ± SD (mm) | ||
|---|---|---|---|---|
| Staphylococcusaureus | Escherichiacoli | Candidaalbicans | ||
| AgNPs-FCg | 2 | 10.53 ± 0.57 | 9.89 ± 0.56 | 7.52 ± 0.11 |
| 5 | 11.24 ± 0.83 | 10.54 ± 0.59 | 8.12 ± 0.16 | |
| 9 | 12.05 ± 0.58 | 11.29 ± 0.45 | 9.02 ± 0.10 | |
| AgNPs-LCg | 2 | 10.10 ± 0.08 | 7.85 ± 0.18 | 7.37 ± 0.29 |
| 5 | 10.48 ± 0.23 | 8.18 ± 0.13 | 7.95 ± 0.26 | |
| 9 | 10.60 ± 0.22 | 8.40 ± 0.33 | 8.90 ± 0.25 | |
| Control | 17.74 ± 0.28 a | 19.45 ± 0.69 b | 10.20 ± 0.12 c | |
Publisher’s Note: MDPI stays neutral with regard to jurisdictional claims in published maps and institutional affiliations. |
© 2022 by the authors. Licensee MDPI, Basel, Switzerland. This article is an open access article distributed under the terms and conditions of the Creative Commons Attribution (CC BY) license (https://creativecommons.org/licenses/by/4.0/).
Share and Cite
Kemala, P.; Idroes, R.; Khairan, K.; Ramli, M.; Jalil, Z.; Idroes, G.M.; Tallei, T.E.; Helwani, Z.; Safitri, E.; Iqhrammullah, M.; et al. Green Synthesis and Antimicrobial Activities of Silver Nanoparticles Using Calotropis gigantea from Ie Seu-Um Geothermal Area, Aceh Province, Indonesia. Molecules 2022, 27, 5310. https://doi.org/10.3390/molecules27165310
Kemala P, Idroes R, Khairan K, Ramli M, Jalil Z, Idroes GM, Tallei TE, Helwani Z, Safitri E, Iqhrammullah M, et al. Green Synthesis and Antimicrobial Activities of Silver Nanoparticles Using Calotropis gigantea from Ie Seu-Um Geothermal Area, Aceh Province, Indonesia. Molecules. 2022; 27(16):5310. https://doi.org/10.3390/molecules27165310
Chicago/Turabian StyleKemala, Pati, Rinaldi Idroes, Khairan Khairan, Muliadi Ramli, Zulkarnain Jalil, Ghazi Mauer Idroes, Trina Ekawati Tallei, Zuchra Helwani, Eka Safitri, Muhammad Iqhrammullah, and et al. 2022. "Green Synthesis and Antimicrobial Activities of Silver Nanoparticles Using Calotropis gigantea from Ie Seu-Um Geothermal Area, Aceh Province, Indonesia" Molecules 27, no. 16: 5310. https://doi.org/10.3390/molecules27165310
APA StyleKemala, P., Idroes, R., Khairan, K., Ramli, M., Jalil, Z., Idroes, G. M., Tallei, T. E., Helwani, Z., Safitri, E., Iqhrammullah, M., & Nasution, R. (2022). Green Synthesis and Antimicrobial Activities of Silver Nanoparticles Using Calotropis gigantea from Ie Seu-Um Geothermal Area, Aceh Province, Indonesia. Molecules, 27(16), 5310. https://doi.org/10.3390/molecules27165310

